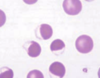

hematology Flashcards
(31 cards)
macrocytic
increase in mean corpuscular volume (due to release of reticulocytes, as a result of anemia)
hypochromic
reduction in corpuscular haemoglobin concentration (MCHC) due to anaemia
FeLV
Feline leukemia virus 貓白血病
- highly infectious retrovirus disease (including vertical transmission)
- recover is possible, otherwise, virus infect bone marrow, and attack wide variety of white blood cells
- lymphoma is the last stage
- leukopenia, decreased Packed Cell Volume (PCV) and Total Protein (TP) levels due to anemia, hemoconcentration and hypoglycemia due to vomiting and diarrhea, electrolyte imbalance caused by dehydration and anorexia, and recurrent urinary tract infections
- while the feline leukemia virus may cause symptomatic illness in an infected cat, an FIV infected cat can remain completely asymptomatic its entire lifetime
Autoagglutination
多個紅血球聚集在一起,而被儀器當作是一個大的RBC
increase in MCV
什麼品種的狗有不一樣的MCV
秋田犬天生MCV較小
(貴賓狗的MCV天生較大)
lipaemia leads to increase or decrease in MCHC?
Lipemia是白色,會增加顏色。因而在使用比色法測定MCHC時,會使測得的數值變高。
Heinz body 是因為方法學上的缺陷而會使測得的 MCHC 較高。
regenerative anemia and MCHC
decrease in MCHC, since it increases the release of reticulocytes, with lower Hb concentration
iron deficiency and MCHC and MCV
Iron deficiency –> decrease in synthesis of Hb
–>extra cell division occurs (cell division is inhibited when Hb reaches various amount)
–> decrease in MCHC and MCV
aged blood sampel and MCV/MCHC
increase in MCV: swelling of RBC
decrease in MCHC: increase in PCV
hyponatraemia and MCV/MCHC
hyponatraemia: low calcium concentration
decrease in MCV: fluid move out of cell due to a lower Na content in the cell
as a result, the PCV will decrease, and hence MCHC increases
intravascular haemolysis and MCHC
increase MCHC: RBC decreases, PCV then also falls. Hb remains the same.
form of reticulocyte in dogs and cats
- aggregate form: larger than mature red cells and contain large clumps of aggregated ribosome; in dogs, all reticulocytes are in this form
- punctate form: more mature form, similar size to RBC, fewer inclusion and contain dots of residue RNA; both forms found in cats; counted as mature RBC
- when counting reticulocytes, only count aggregate form
- increased punctate reticulocytes indicate a regenerative response 2–4 weeks earlier, while increased aggregate reticulocytes indicate recent bone marrow stimulation.
Parvovirus and disease
non-enveloped single-stranded DNA virus
highly contigious in dogs, spread by fecal route
parvovirus喜歡一直在分裂的細胞(像是腸道等等)。Parvovirus對年輕動物也可能造成leukopenia;或是攻擊bone marrow。(因為bone marrow也一直在分裂);或造成幼犬的心肌產生問題。
causing non-regenerative anaemia
Because the normal intestinal lining is also compromised, blood and protein leak into the intestines, leading to anemia and loss of protein, and endotoxins escape into the bloodstream, causing endotoxemia.
Azotemia
Azotemia is a condition that occurs when your kidneys have been damaged by disease or an injury. You get it when your kidneys are no longer able to get rid of enough nitrogen waste.
Azotemia is usually diagnosed by using urine and blood tests. These tests will check your blood urea nitrogen (BUN) and creatinine levels.
Neonatal isoerythrolysis
- IMHA
- Type B cats have a naturally occurring high titre of anti-A antibodies, which in the lactating queen enter the colostrum and after suckling are absorbed into the kitten’s bloodstream in the first 48 hours of life. Depending on the amount ingested, these antibodies cause severe haemolytic anaemia intravascular haemolysis, haemoglobinuria and icterus, and may lead to sudden death
Haemolytic anaemia associated with infections
- Haemotrophic Mycoplasma infections in cats
- FeLV: weakening immunity so secondary infection is also possible
- babesia
Canine babesiosis
- infection in Babesia: protozoan parasite budding in RBCs
- large form: B. vogeli / canis
small form:B. gibsoni
transmission by tick
- intravascular and extravascular
haemolysis (and thus a regenerative anaemia) and, depending on the strain, can lead to moderate anaemia or marked anaemia - haemoglobinuria, haemoglobinaemia and jaundice
Heinz bodies
- haemolysis as a result due to oxidative damage, etc exposure to onions, paracetamol, vitamin K, etc
- in cats, can develop in assiciation of hepatic lipidosis
- cats are more likely to develop this
- 補充:Zinc&萘,會造成血管內溶血(membrane damage)或少量 HB、MetHb in dogs & cats
- *MetHb: 變性血紅素,Fe2+變 Fe3+
- Eccentrocyte(偏紅血球):HB 跑到一側,RBC 另一側蒼白,代表有嚴重氧化傷害
結果
- Reducing deformability –> entrapped in sinusoids of spleen –> extravascular haemolysis大部分
- Membrane permeability altered –> osmotic swelling –> intravascular hemolysis離心後呈現咖啡色
- Regenerative anaemia, often a neutrophilia and monocytosis
- In cats, more readily formed. Not always associated with anaemia
- Resulting in falsely high Hb (and hence MCHC)
Eccentrocyte
Eccentrocyte (偏紅血球):HB 跑到一側,RBC 另一側蒼白,代表有嚴重氧化傷害
oxidative injury to direct membrane damage
MetHb
- 變性血紅素,Fe2+變 Fe3+,leading to hypoxia and chocolate-brown blood
refeeding syndrome
- 代謝問題hepatic lipidosis。此時若急於給予食物易會造成低血磷、電解質不平衡
hypophosphatemia
- 常見在貓的DKA(糖尿病酮酸中毒)
- Depletion of ATP, increased red cell rigidity and haemolysis
- 低血磷造成 RBC 易碎凋亡而溶血
- 犬貓注射胰島素後可能發生
- 常見於DM(Diabetes mellitus)的貓,胰島素除了bind glucose channel讓葡萄糖進去,同時也會讓鉀離子、磷離子進入細胞內,因此DM不要急著打胰島素。
- 有厭食症(Anorexic)的貓,因一段時間沒進食,造成肝臟內脂肪的堆積,導致有肝臟脂肪的
普拿疼中毒 Paracetamol toxicity
- 貓咪得 calicivirus, herpesvirus,有的醫生看見上呼吸道感染就給中和感冒藥而致死
- 貓吃一顆(500mg)普拿疼就掰掰了
- 組織缺氧hypoxia造成MetHb
- 離心後紅血球呈「棕紅色」chocolate brown(30~40%的Hb是metHb),當MetHb超過
- 80%就能致死
Endocrine and anemia
(1)Thyoxin、Growth hormone都會造成EPO效果增強。
(2)Estrogen與「過量」的cortisol會抑制EPO的釋放。Cortisol其中之一個功能為促進身體代謝。因此,當cortisol在適當範圍內增加的話,對紅血球的製造是正向提升的。
(3)低甲狀腺功能的貧血通常是輕微的。
(4)hypoadrenocorticism 狗的腎上腺皮質激素低下症:狗會貧血,是因為低腎上腺皮質素造成GI hemorrhage。(治療給予類固醇,但是類固醇給予過多也可能會造成GI hemorrhage,老師自己就碰過一次,所以類固醇的使用是一個範圍的)
Anemia Of inflammatory disease
- Cause: AID – Anemia of Inflammatory Disease
(1)非常常見之造成非再生性貧血的原因
(2)可在感染後3-10天內發現 (RBC life spans)
(3)可造成Inflammation,tissue injury,immune-mediated process或是Neoplasia
(4)輕微到重度的症狀都有【PCV25-36% in dogs;19-26 in cats】,但臨床症狀不明顯。除非是溶血性貧血才會有咖啡色尿液
(5)主要影響機制:
- 造成Iron缺乏
- 縮短RBC的存活期,氧化增加造成傷害/Ig binding
- 減少EPO的釋放:有些cytokine(IL-1、TNF)會影響EPO,影響機制不清楚。
- Increased production of hepcidin: hormone decreases bioavailability of iron by limiting dietary absorption and mobilization from iron stores; acute phase protein and increases in both acute and chronic systemic inflammation as a result of IL-1 and IL-6


